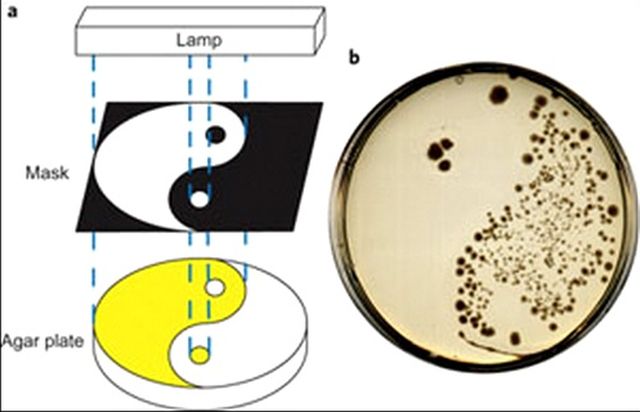

Ученые и андролог обнаружили, что с помощью дополнительной химгруппы, которая проходит режим метаморфозы из одного изомера в другой, становится возможным включать и выключать антибиотик, к которому химическая группа присоединена.
Как известно, антибиотики защищают организм человека от инфекций, однако лишь в случае, если выбранный курс полностью окончен и не прерывался. В противном случае, выходит на первый план иная сторона антибиотиков, а именно – они являются причиной появления устойчивых бактерий, которые оказываясь в окружающей среде быстро приспосабливаются

Отдельно можно выделить те антибиотики, которые массово используются в сельском хозяйстве для профилактики скота. В результате, попадая в сточные воды, лекарства становятся катализатором возникновения новых штаммов, наделенных большей живучестью.
Этой проблемой решили заняться исследователи из Гронингенского университета (Нидерланды). Вся их работа основана на желании найти возможность «включать» и «выключать» антибиотик тогда, когда это нужно для того, что бы лекарство работало лишь определенное количество времени. Само собой уже существуют самораспадающиеся вещества, однако их проблема заключается в отсутствии точного контроля.
Собственно, это проблему исследователи и решали. Результатом их работы стало создание лекарства с точной настройкой, ученым удалось прикрепить к молекуле антибиотика химическую фоточувствительную группу для того, что бы антибиотик реагировал на свет. Само собой разумеется подобное вмешательство в молекулярную структуру влечет за собой изменения свойств самой молекулы, так что параллельно ученым пришлось создать еще несколько вариантов антибиотика пока не достигли желаемого результата.
Вкратце расскажем о том, как работает вся схема – фоточувствительная группа, присоединенная к необходимому антибиотику, входила в фазу цис-транс-изомерноего состояния после воздействия света. То есть, перешла из транс-изомера в цис-изомер. Первое состояние характеризовалось состоянием «сна», второе состояние – «бодрствование». Общее время активной фазы длилось два часа в среде, где температура соответствовала температуре тела человека, по истечению этого времени химическая группа «выключалась» окончательно.
Плюсы подобного антибиотика от обыкновенного довольно очевидны, начиная от тех, которые были перечислены выше, заканчивая тем, что теперь препарат может «включаться» как раз в тот момент, когда попадает в нужной части организма, а стало быть, увеличится эффективность самого препарата. К слову сказать, по мнению исследователей, подобные средства уже сейчас входят в микробиологическую научную практику, что поможет найти более интересные и удобные подходы к вопросам и проблемам, интересующие ученых, однако до клинического использования подобных препаратов еще далеко. По предварительным прогнозам пройдет примерно десяток лет, прежде чем на полках аптек появятся подобного рода антибиотики.



Еще бы и продавали настоящие лекарства, а не подделки, сейчас вал низкокачественных медпрепаратор из Индии, зато упаковка красивая и названия умные 🙁
Такие лекарства как антибиотики надо принимать очень и очень внимательно, особенно, если речь идет о детском здоровье, сколько страшных историй про это слышала, иногда думаешь, ну откуда такие напасти берутся?